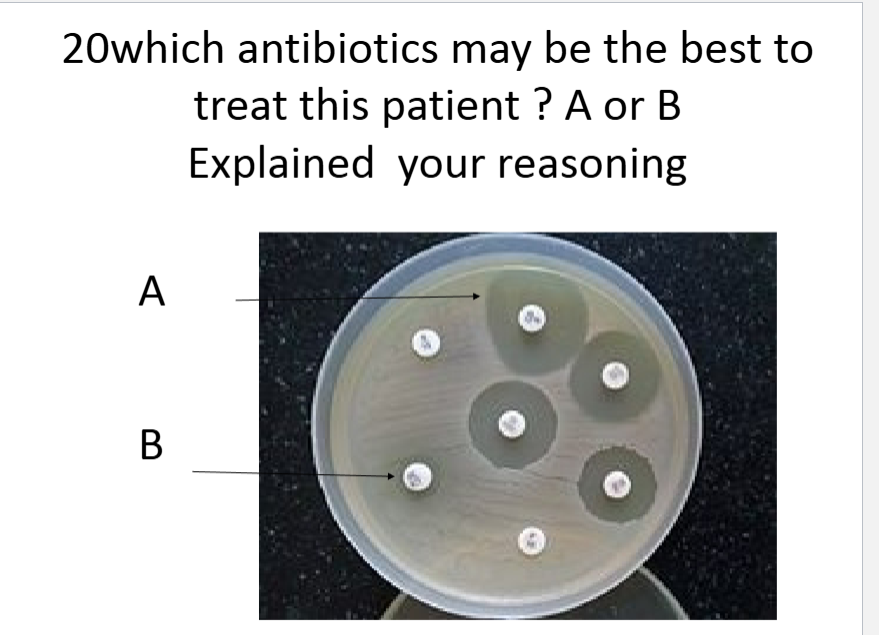
term image

1/59
random shit from labs + the full module practice (sipping big fucking squidward fuck is you fucking talking about boy)
Name | Mastery | Learn | Test | Matching | Spaced | Call with Kai |
|---|
No analytics yet
Send a link to your students to track their progress

what is this
sporangium, looks like a sperm cell

what process is happening
Zygosporangium conjugation

What is this
Saccharomyces, budding=small daughter cells attached

organism / structure
peziza apothecium / ascocarp

organism / structure
corpinus mushroom / cap of club fungus single unit

organism / structure
corpinus mushroom / cap of club fungus

what type of lichen
fruticose, fully 3d

what type of lichen
foliose, slightly 3d but mostly flat

what type of lichen
crustose, crusted on

what is this
rhizopus sporangium ( bread mold
broadest category
bacteria archaea eukarya
kingdoms
2nd, animals plants fungi
phylum
3rd

what is this how does it move
amoeba, psuedopods

what is this
diatom, can tell from symetrical shapes, clear outline, phototroph, they use photosynthesis

what is this / function
capsule, protection

lichen / fungus

volvox

Spirogyra, eukaryotic green alga, looks like a ladder, spiral ribbon like chloroplasts.

shelf fungus / fungi

Morel mushroom

Trypanosoma, can tell from blood cells in bg, trypanosomiasis

blade / stipe / holdfast

paramecium. long oval shaped, cilia along edge, slipper shape


volvox

spirogyra

spirogyra, spirals in each cell, longer compared to spiriulm

Oedogonium, boxy cells stacked with some circles in between. oogonia with oospore

paramecium conjugation


Sporangium, specialized structure in plants, fungi, and algae that produces and contains spores for reproduction

penicillin digitatum, fungus found in soil of citrus producing areas

Lichen, hybrid colony growing among filament, layered,

zygospore, identified from two hyphal suspensors on each side (“wings”)

hydrodictyon, looks like a net

euglena
flagellum-a
eyespot-b
contractile vacuole-c
chloroplast-d
antibiotic a, has a larger zone, bacteria wouldn’t grow there

staphylococci, staphyl=grape pattern, cocci=spherical bacteria

strepetobacillius, strepeto=chain arrangement, bacillius =rod shaped

spirillum, numerous organisms, thin, worm like

38mm, larger zone of inhibition

what / type
fruticose / lichen

what / group
puffball / club fungus

top down / function
fruiting body = reproductive structure
mycellium = network of hyphae
hyphae = thin filaments absort nutrient
how to identify crustose
looks like painted surface
how to identify foliose lichen
leaf like
how to identify fruticose lichen
branching hair like

what lichen
foliose

microscopic antomy of lichen
what do these structures do

tell me wut it is / structure partner
euglena, top down is flagellum, reservoir, stigma, chloroplast

wut dis
paramecium conjugation

stentor, shit looks like a trumpet fam

label top down
blade float stipe holdfast

volvox

gloeocapsa

gloeocapsa, looks like volvox, this is smaller, no tiny dots
think glo gang, glo gang doesnt have many members like haunted mound (volvox), haunted mound wants to be volvox

oscillatoria, looks like stacked coins
victoria is poor she needs coins

bacillus

anabaena, ana is a bae who likes to make bracelts